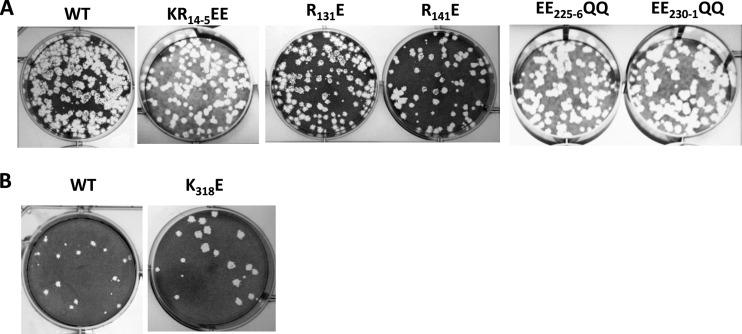
https://cdn.ncbi.nlm.nih.gov/pmc/blobs/ca46/6384066/b9bc00db7a55/JVI.02023-18-f0003.jpg

蓝舌病病毒 VP6 与基因组 RNA 的相互作用对基因组包装至关重要。
The Interaction of Bluetongue Virus VP6 and Genomic RNA Is Essential for Genome Packaging.
机构信息
Faculty of Infectious and Tropical Diseases, London School of Hygiene and Tropical Medicine, London, United Kingdom.
Biotechnology Program, Indiana University Bloomington, Bloomington, Indiana, USA.
出版信息
J Virol. 2019 Feb 19;93(5). doi: 10.1128/JVI.02023-18. Print 2019 Mar 1.
The genomes of the , including the animal pathogen bluetongue virus (BTV), are multisegmented double-stranded RNA (dsRNA). During replication, single-stranded (ss) positive-sense RNA segments are packaged into the assembling virus capsid, triggering genomic dsRNA synthesis. However, exactly how this packaging event occurs is not clear. A minor capsid protein, VP6, unique for the orbiviruses, has been proposed to be involved in the RNA-packaging process. In this study, we sought to characterize the RNA binding activity of VP6 and its functional relevance. A novel proteomic approach was utilized to map the ssRNA/dsRNA binding sites of a purified recombinant protein and the genomic dsRNA binding sites of the capsid-associated VP6. The data revealed that each VP6 protein has multiple distinct RNA-binding regions and that only one region is shared between recombinant and capsid-associated VP6. A combination of targeted mutagenesis and reverse genetics identified the RNA-binding region that is essential for virus replication. Using an RNA-binding competition assay, a unique cell-free assembly assay, and an single-cycle replication assay, it was possible to identify a motif within the shared binding region that binds BTV ssRNA preferentially in a manner consistent with specific RNA recruitment during capsid assembly. These data highlight the critical roles that this unique protein plays in orbivirus genome packaging and replication. Genome packaging is a critical stage during virus replication. For viruses with segmented genomes, the genome segments need to be correctly packaged into a newly formed capsid. However, the detailed mechanism of this packaging is unclear. Here we focus on VP6, a minor viral protein of bluetongue virus, which is critical for genome packaging. We used multiple approaches, including a robust RNA-protein fingerprinting assay, to map the ssRNA binding sites of recombinant VP6 and the genomic dsRNA binding sites of capsid-associated VP6. By these means, together with virological and biochemical methods, we identify the viral RNA-packaging motif of a segmented dsRNA virus for the first time.
包括动物病原体蓝舌病毒 (BTV) 在内的呼肠孤病毒的基因组是多节段双链 RNA (dsRNA)。在复制过程中,单链 (ss) 正链 RNA 片段被包装到正在组装的病毒衣壳中,引发基因组 dsRNA 合成。然而,这种包装事件的确切发生机制尚不清楚。一种称为 VP6 的次要衣壳蛋白,是呼肠孤病毒所特有的,据推测它参与了 RNA 包装过程。在这项研究中,我们试图描述 VP6 的 RNA 结合活性及其功能相关性。利用一种新的蛋白质组学方法来绘制纯化重组蛋白的 ssRNA/dsRNA 结合位点和衣壳相关 VP6 的基因组 dsRNA 结合位点。数据显示,每个 VP6 蛋白都有多个不同的 RNA 结合区域,而重组和衣壳相关 VP6 之间只有一个区域是共享的。通过靶向突变和反向遗传学组合,确定了对病毒复制至关重要的 RNA 结合区域。使用 RNA 结合竞争测定、独特的无细胞组装测定和单循环复制测定,能够鉴定出在衣壳组装过程中优先结合 BTV ssRNA 的共享结合区域内的一个基序,这与特定 RNA 的募集一致。这些数据突出了这种独特蛋白在呼肠孤病毒基因组包装和复制中的关键作用。基因组包装是病毒复制的一个关键阶段。对于具有分段基因组的病毒,基因组片段需要正确包装到新形成的衣壳中。然而,这种包装的详细机制尚不清楚。在这里,我们专注于蓝舌病毒的次要病毒蛋白 VP6,它对基因组包装至关重要。我们使用了多种方法,包括一种强大的 RNA-蛋白质指纹图谱测定,来绘制重组 VP6 的 ssRNA 结合位点和衣壳相关 VP6 的基因组 dsRNA 结合位点。通过这些方法,结合病毒学和生化方法,我们首次鉴定了一种分段 dsRNA 病毒的病毒 RNA 包装基序。